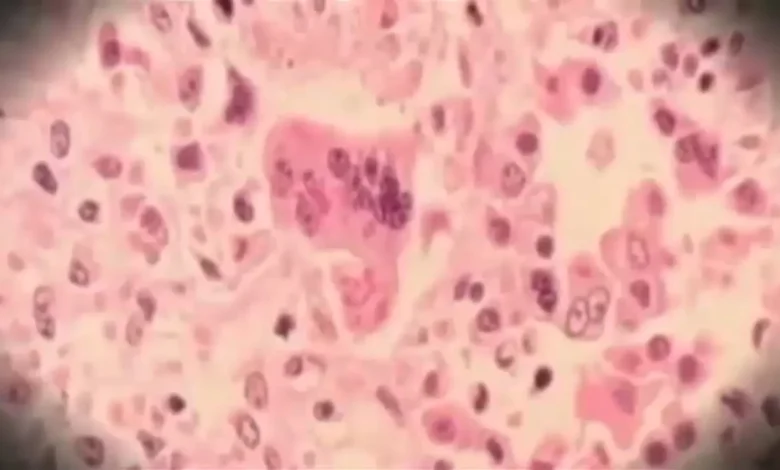

Measles Exposure Alert Issued by New Jersey Health Department at Newark Airport
Officials from New Jersey’s Health Department have issued a measles exposure alert concerning Newark Airport. This warning follows the presence of an individual with measles who was in the airport on Friday, December 19.
Details of Measles Exposure at Newark Airport
The infected person was in terminals B and C from 7 a.m. to 7 p.m. on that day. Officials are working to identify individuals who may have been in contact with this person during their time at the airport.
Health Recommendations
The Health Department strongly advises anyone who is not vaccinated to receive the MMR vaccination. This vaccine provides protection against measles, mumps, and rubella.
Measles Symptoms to Watch For
Measles can lead to serious health issues. Symptoms typically manifest about 10 to 14 days after exposure and include:
- High fever
- Cough
- Runny nose
- Watery red eyes
- A rash that appears three to five days after the onset of symptoms
The rash often begins as flat red spots on the face at the hairline, spreading downwards to the neck, torso, arms, legs, and feet.
Public Health Alert
Given the highly contagious nature of measles, it is crucial for the community to stay informed and vigilant. Those who believe they may have been exposed should monitor their health and contact a healthcare provider if symptoms develop.



